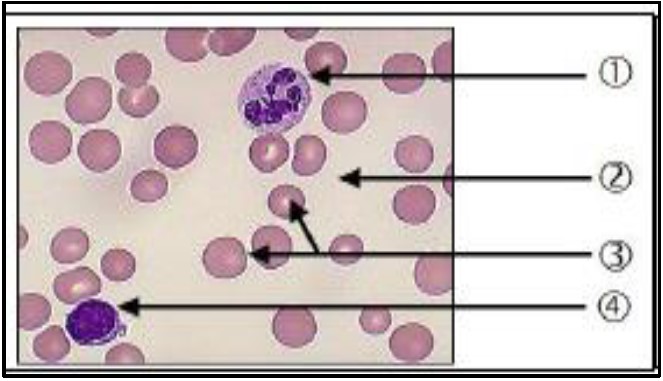

SVT 3AC -Devoir Corrigé N2 Semestre 1
MODÈLE N° 1
Niveau : 3ème APIC/P
•
Durée : 1 Heure
1 Reliez par flèche chaque terme à sa définition appropriée :
2 Répondez par vrai ou faux :
3 Légendez la figure suivante :
4 Citez deux dangers qui menacent l’appareil respiratoire humain :
1 Exercice 1 : Échanges gazeux respiratoires
Le document ci-dessous représente le mécanisme responsable des échanges gazeux respiratoires au niveau des alvéoles pulmonaires
2 Exercice 2 : Étude de cas médical
Youssef est un étudiant du collège. Pendant l’exercice du sport, il présentait les symptômes suivants: sensation de fatigue pendant l’effort et pâleur du visage. Des tests médicaux et sanguins ont donc été effectués pour lui, et les résultats ont été les suivants:
| Composition du sang | Personne normale | Personne malade |
|---|---|---|
| Nombre des globules rouges dans 1 mm³ du sang | 5 000 000 | 3 000 000 |
| Quantité d’hémoglobine par g/ml | 18 | 10 |
🔒 Abonnez-vous pour accéder aux corrections détaillées de ce devoir.
MODÈLE N°2
Niveau : 3ème APIC/P
•
Durée : 1 Heure
Restitution des connaissances 8 points
1- Répondre par vrai ou faux 2pts
– L’air inspiré est formé seulement de dioxyde de carbone:
– Les échanges gazeux entre les cellules et le sang s’effectuent au niveau des alvéoles pulmonaires:
– Les organes consomment le dioxyde de carbone et rejettent le dioxygène:
– Les besoins alimentaires d’une femme enceinte sont les mêmes qu’une femme normale:
2- Relier par des flèches entre les éléments du groupe A avec ceux du groupe B 2pts
| Groupe A | Groupe B |
|---|---|
| – La ration alimentaire | – Danger qui menace l’appareil respiratoire. |
| – L’asthme | – Quantité d’aliments nécessaire pour l’organisme durant 24 heures. |
| – La sclérose de l’œil | – Carence en fer. |
| – L’anémie | – Carence en vitamine A |
3- Le doc 1 présente un schéma de l’appareil respiratoire chez l’homme, écrire le nom qui correspond à chaque flèche 2pts

4- Complète le texte par les termes suivants 2pts
Termes à utiliser : différences de pression – l’air alvéolaire – dioxygène – dioxyde de carbone
Le raisonnement scientifique et communication écrite et graphique 12 points
Exercice 1 8pts
Le Doc 1 représente le mécanisme responsable des échanges gazeux respiratoires au niveau des organes :
1- Comparer la pression partielle de dioxygène (PO₂) entre le sang entrant dans l’organe et les cellules : 1pt

2- Déduire le sens de diffusion de dioxygène (O₂), et indiquer ce sens par une flèche rouge : 2pts
3- Comparer la pression partielle de dioxyde de carbone (PCO₂) entre le sang entrant dans l’organe et les cellules : 1pt
4- Déduire le sens de diffusion de dioxyde de carbone (CO₂), et indiquer ce sens par une flèche bleue : 2pts
Le Doc 3 présente le devenir d’O₂ et l’origine de CO₂ dans la cellule :

5- A partir du doc 3 déterminer :
a – les besoins de la cellule = 0,5pt
b- Que produit la cellule ? 0,5pt
c- Déduire le devenir d’O₂ et l’origine de CO₂ : 1pt
Exercice 2 4pts
Un adolescent de 15 ans a consommé pendant 24 heures une ration alimentaire composée de : -102g de Protides – 450g de Glucides – 84g de Lipides.
1- Sachant que 1 g de glucides libère 17 kJ, et 1 g de protéines libère 17 Kj et 1 g de lipides libère 38 kJ. Calculer l’apport énergétique (énergie totale) qu’offre la ration de cet adolescent : 2pts
| Énergie des glucides | Énergie des protides | Énergie des lipides | Énergie totale |
|---|---|---|---|
2- Sachant que cet adolescent a besoin d’une énergie de 12180 Kj par jours, est ce que l’énergie déduite par les aliments consommés satisfait ses besoins ? Justifiez votre réponse. 2pts
🔒 Abonnez-vous pour accéder aux corrections détaillées de ce devoir.
MODÈLE N° 3
Niveau : 3ème APIC
•
Durée : 1 Heure
Partie 1 : Restitution des connaissances 8 points
Exercice 1 : Répondez par VRAI ou FAUX 2pts
| La source de lymphe interstitielle est le sang. | |
| Asthme est une maladie respiratoire. | |
| La respiration cellulaire se fait au niveau des poumons. | |
| Lymphe interstitielle joue le rôle d’intermédiaire entre le sang et les alvéoles |
Exercice 2 : Relier les éléments suivants 2pts
Éléments à relier :
– Plasma
– Plaquettes sanguines
– Hématies
– Globules blancs
Définitions :
– Liquide contenant les cellules sanguines
– Son rôle est la coagulation du sang
– Cellules sans noyau de couleur rougeâtre
– Cellules transparentes
Exercice 3 : Compléter les phrases par les mots suivants 2pts
Mots à utiliser : nutriments – hémoglobine – oxyhémoglobine – carbaminohémoglobine – lymphe
– Le sang contient …………………. ,qui est responsable de sa coloration rouge.
– La combinaison du sang avec le CO₂ forme ………………….
– La coloration claire du sang due à la formation du ………………….
– Le plasma contient des ………………….
Exercice 4 : Légender le schéma suivant 2pts

Partie 2 : Raisonnement scientifique et communication écrite et graphique 12 points
Exercice 1 6pts
Le schéma suivant montre une structure responsable des échanges gazeux respiratoires au niveau des poumons

1- Légender le schéma 1 et 2 1,5pts
2- Déterminer le sens du mouvement de O₂ ? Justifier votre réponse ? 1,5pts
3- Déterminer le sens du mouvement de CO₂, justifier votre réponse 1,5pts
4- Sur le schéma, avec une flèche verte montrer le sens du mouvement du O₂, et une flèche bleue pour le sens du CO₂ 1pt
Exercice 2 6pts
Le document 2 présente la concentration d’O₂ et de CO₂ du sang entrant au muscle et le sang sortant du muscle au niveau de l’artère et la veine.

1- Comparer la quantité d’O₂ et de CO₂ du sang entrant au muscle et le sang sortant du muscle 2pts
O₂ : …………………………………………………………………………………………………
CO₂ : …………………………………………………………………………………………………
2- Que peut-on conclure ? 2pts
3- Lors de son activité, le muscle consomme du glucose aussi, déterminer le phénomène résultant et sa réaction chimique 2pts
Bonne chance !
Remarque : 0,5 pt pour la bonne organisation de la feuille
🔒 Abonnez-vous pour accéder aux corrections détaillées de ce devoir.
MODÈLE N°4
Niveau : 3ème APIC/P
•
Durée : 1 Heure
RESTITUTION DES CONNAISSANCES 8 points
I. Relier par des flèches les éléments du groupe A avec ceux du groupe B 2pts
Groupe A
– Rachitisme
– Ration alimentaire
– Anémie
– Kwashiorkor
Groupe B
– Carence en protéines
– Quantité d’aliments consommés en 24h
– Carence en fer
– Carence en vitamine D
II. Indiquer parmi les mots suivants le terme scientifique convenable pour chaque définition 3pts
Mots à utiliser : Carences alimentaires – Réactif – Enzyme – Hydrolyse – Chyle intestinal – Vaisseau lymphatique
| N° | Définitions | Terme scientifique convenable |
|---|---|---|
| 1 | Contient : acides aminés, Glucose, Acides gras, Eau, Sels minéraux, Glycérol, Vitamines et Cellulose | |
| 2 | Réaction chimique que subissent les aliments simples en présence d’eau et d’enzymes spécifiques | |
| 3 | Substance chimique qui met en évidence l’existence de nouveaux éléments dans la substance testée | |
| 4 | Vaisseau qui transporte les substances issues des lipides traversant la paroi de l’intestin grêle | |
| 5 | Substance protéinique entre dans la simplification moléculaire de l’aliment et réagit à l’acidité du PH et à la température | |
| 6 | Maladies de malnutrition dues au manque d’un aliment simple au moins dans l’alimentation |
III. Le document ci-dessous représente une partie du système digestif de l’homme 3pts
RAISONNEMENT SCIENTIFIQUE ET COMMUNICATION ÉCRITE ET GRAPHIQUE 12 points
IV. Calcul d’apport énergétique 4pts
Un adolescent de 15 ans a consommé pendant 24 heures, une ration alimentaire composée des éléments suivants :
| Lipides 84g | Glucides 450g | Protides 102g |
|---|---|---|
| Phosphore 250 mg | Calcium 1200 mg | Eau 1500g |
1) Calculer l’apport énergétique (énergie totale) qu’offre la ration de cet adolescent
Sachant que : 1g de glucides = 17kj, 1g de lipides = 38kj et 1g de protides = 17kj.
2) Sachant que l’adolescent a besoin quotidiennement en énergie à 12540kj.
Comparer l’apport alimentaire avec les besoins en énergie pour cet adolescent
3) Déduire est ce que cette ration suffit pour l’adolescent à couvrir ses besoins énergétiques
V. Échanges entre un muscle et du sang 4pts
| Informations générales | Consommation de dioxygène(ml) | Consommation de glucose(mg) | Rejet de dioxyde de carbone(ml) |
|---|---|---|---|
| Muscle au repos | -5ml | -3mg | +12ml |
| Muscle en activité | -16ml | -10mg | +20ml |
| Activité – Repos | -11ml | -7mg | +8ml |
1°- Compare la quantité d’O₂ et du glucose dans le muscle au repos et en activité 2pts
O₂
GLUCOSE
2°- Formuler une hypothèse pour expliquer l’augmentation de la consommation de dioxygène (O₂) et de glucose lorsqu’un organe est en activité 1pt
3- Exprimer par réaction le résultat de la consommation de dioxygène et du glucose au niveau du muscle 1pt
VI. Action du suc pancréatique sur le blanc d’œuf 4pts
Expérience :
• Tube A : eau + cubes de blanc d’œuf
• Tube B : eau + cubes de blanc d’œuf + suc pancréatique
• Tube C : eau + fines particules de blanc d’œuf
• Tube D : eau + fines particules de blanc d’œuf + suc pancréatique
Les quatre tubes sont placés à 37°C pendant 2 heures

1) – Dans cette expérience quel est l’intérêt des tubes A et C? 1pt
2) – Que s’est il passé dans le tube D? proposez une explication. 1pt
3) – Que s’est il passé dans le tube B? Comment expliquez-vous les différences entre les résultats observés dans les tubes B et D? 1pt
4-) Quel est l’intérêt du broyage des aliments dans la bouche et de leur brassage dans l’estomac? 1pt
🔒 Abonnez-vous pour accéder aux corrections détaillées de ce devoir.
SVT 3AC -Devoir Corrigé N2 Semestre 1

